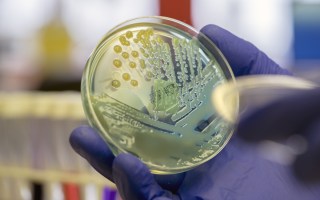

Federal politicians form refugees support group
Expectations are high for the federal parliament’s newly formed refugee support group. Almost 50 senators and MPs from various parties have joined...

Optus breach teen scammer avoids jail
A 20-year-old man has evaded a potentially decade-long jail sentence after trying to scam $2000 from Optus customers affected by its September...

Woman jumps from burning Sydney unit block
A woman has escaped a fire by jumping from the second storey of a unit complex while her pet cat has received oxygen treatment....

Tree shortage threatens to ruin Christmas
Even Christmas isn’t safe from La Niña. Aussies keen on a real Christmas tree might be left disappointed this year and 2022’s extreme...

NSW drink-driving rates rise as tests dive
NSW has dropped the ball on policing drunk drivers, a motoring group says, after roadside breath tests in the state halved in...
Vaccine-resistant pneumonia has increased
Cases of vaccine-resistant pneumonia are increasing despite the jab being included in routine childhood immunisations. A national study by the University of...

Australians drop $6.2b on Black Friday bargains
Australians are due to drop $6.2 billion on everything from airfares to eczema cream in Black Friday sales, as unions protest poor...